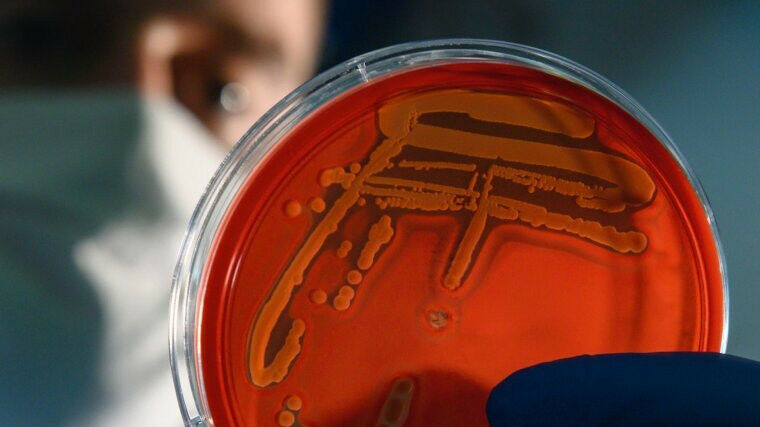

- Life
- Knowledge Transfer and Innovation
Published:
They live in 100 degree hot water, they use radioactivity for their metabolism or survive for millions of years in a kind of "Sleeping Beauty sleep "--microorganisms not only colonise every habitat on earth. They are also amazing survival artists. Above all, however, they and their complex communities play a crucial role for the environment, climate and the health of plants, animals and humans. They keep global food webs and material cycles running, they provide oxygen and bind carbon dioxide in the atmosphere.
The current issue of the research magazine LICHT GEDANKEN focuses on the world of these important microorganisms. It presents researchers from the University of Jena who are investigating how microbial communities control environmental and life processes: for example, the intestinal microbiome, which not only plays a role in illnesses such as diabetes or infections , but also influences human behaviour.
The balance of microbial systems is crucial for all these processes, which is the focus of the Cluster of Excellence "Balance of the Microverse" at the University of Jena. In the LICHT GEDANKEN interview with the cluster’s spokesperson , readers can find out how Jena researchers and their cooperation partners are working to understand and protect the balance of vital microbiomes.
The booklets are available in university buildings and (university) canteens and can be purchased from the university shop.



